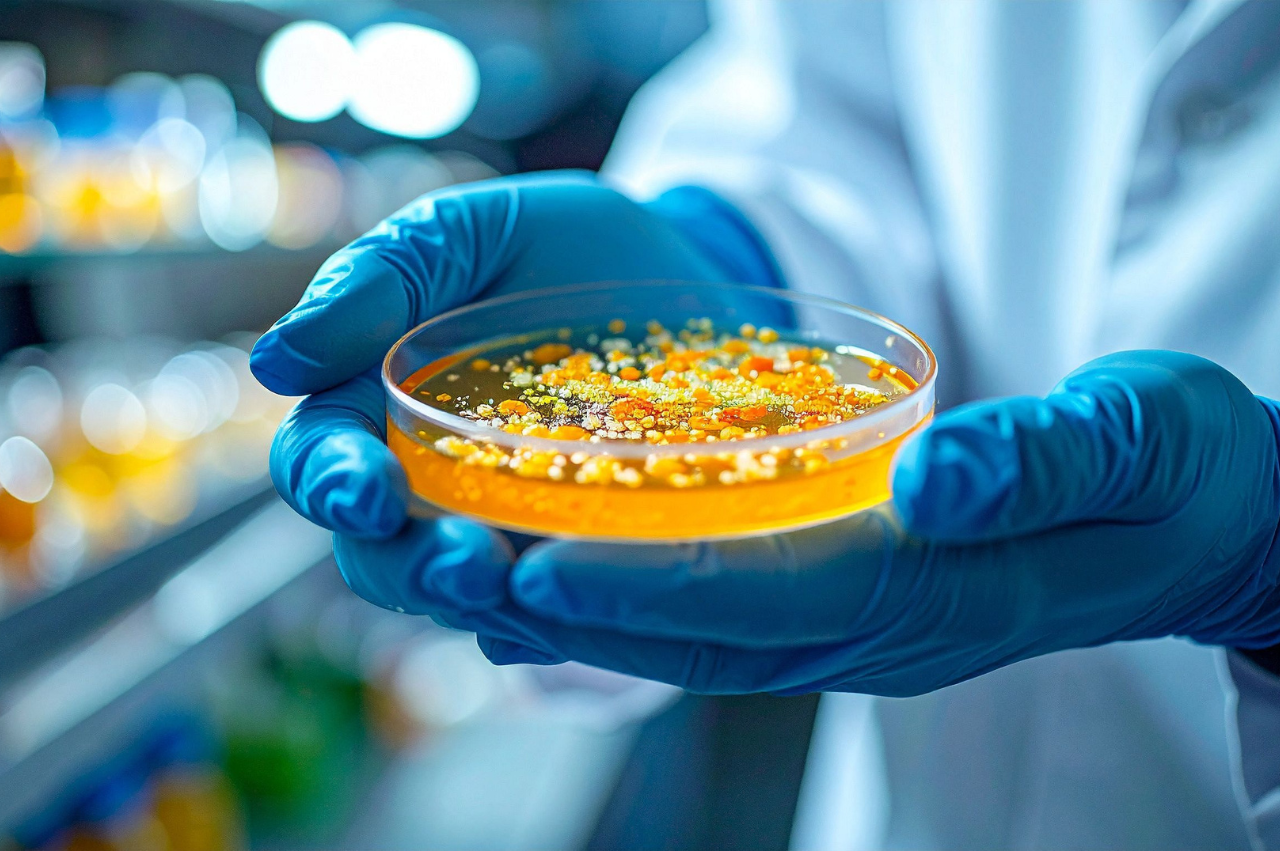

Solution
A comprehensive, decision-ready commercial assessment was delivered, featuring:
Customer & Demand Validation
• Verified identification of high-volume Lumox users across biopharma companies, CROs, and academic institutions in the US and Europe
• Segmentation of customers by usage intensity, application focus, and near-term adoption potential
Distributor & Channel Landscape Mapping
• Detailed mapping of the distributor ecosystem, including global distributors and regional partners
• Analysis of pricing tiers, geographic coverage, and channel control dynamics across sales models
Customer & Distributor Insights
• Synthesis of feedback on testing and validation requirements, pricing sensitivity, purchasing drivers, and switching barriers
• Identification of practical adoption constraints and decision-making criteria
Partnership Readiness Assessment
• Evaluation of distributor interest in a Mitsui/InnoCell partnership, including willingness to promote, stock, and pilot the product
• Assessment of channel incentives and execution expectations
Commercialization & Targeting Strategy
• Shortlisting of priority and secondary customer segments for pilots, demonstrations, and early commercialization efforts
• Actionable recommendations to support focused market entry and go-to-market execution
Methodology
Primary Research:
• Engaged with existing Lumox distributors, including major global distributors and regional channel partners, to gather insights on sales volumes, pricing structures, procurement requirements, and customer segmentation
• Conducted discussions with current and former Sarstedt personnel to validate competitive positioning, channel strategies, and product-specific differentiators
• Identified key end-use applications for Lumox plates and interviewed stakeholders across biopharma companies, CROs, and academic research institutions to understand adoption drivers, purchasing behavior, and unmet needs
• Carried out structured interviews with selected distributors and end users to assess partnership interest, willingness to stock or trial products, and switching likelihood
Secondary Research:
• Reviewed distributor catalogs, product listings, pricing references, and market-facing materials to support and triangulate primary interview findings
• Analysed company disclosures, competitive product information, and market intelligence sources to strengthen understanding of channel dynamics and competitive benchmarks
Client Benefits And
Feedback
• Enabled the client to gain a clear, data-backed understanding of the key drivers behind Lumox sales, allowing focused targeting of high-value customers and distributors
• Provided clarity to prioritize partnership discussions, distributor engagement, and pilot initiatives across the US and Europe
• Delivered actionable insights that helped accelerate commercial momentum and support informed go-to-market decisions